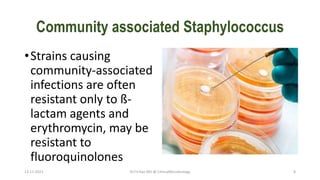
Community associated Staphylococcus
•Strains causing
community-associated
infections are often
resistant only to ß-
lactam agents and
erythromycin, may be
resistant to
fluoroquinolones
13-11-2023 Dr.T.V.Rao MD @ ClinicalMicrobiology 8

The document discusses MRSA (methicillin-resistant Staphylococcus aureus), including what it is, how it develops resistance, types of infections it causes, risk factors, screening and testing methods, and prevention strategies. MRSA is a strain of staph bacteria that is resistant to certain antibiotics like methicillin and oxacillin. Screening high-risk patients and implementing good hand hygiene are effective ways to control the spread of MRSA infections in healthcare settings.

![What do you understand by Vancomycin
Resistance
• Since 1996, MRSA strains
with decreased
susceptibility to
vancomycin (minimum
inhibitory concentration
[MIC], 4 – 8 μg/ml) and
strains fully resistant to
vancomycin (MIC ≥ 32
μg/ml) have been reported.
13-11-2023 Dr.T.V.Rao MD @ ClinicalMicrobiology 22](https://image.slidesharecdn.com/328672341-screening-for-mrsa-by-dr-t-v-rao-md-231113023023-a20e84ee/85/Screening-for-MRSA-by-Dr-T-V-Rao-MD-pptx-22-320.jpg)







